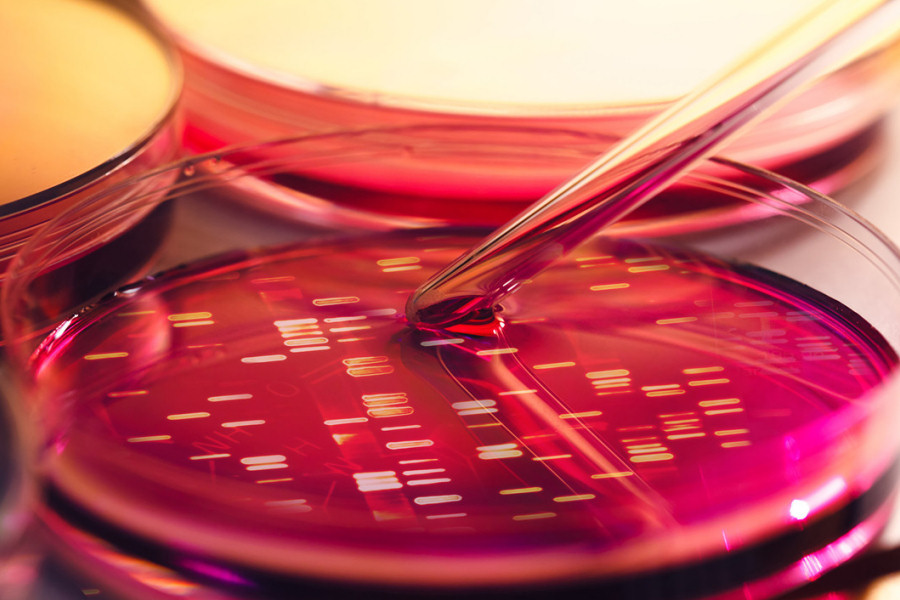

Notiziario LAB "IN FORMA"
Nell’ambito sanitario, le sinergie multidisciplinari tra professionisti, insieme ad una comunicazione efficace, empatica, onesta e trasparente, risultano fondamentali per il buon esito dei percorsi assistenziali e per la riduzione del rischio clinico.
Con questa Newsletter, il Laboratorio Analisi Cliniche Iperione, in collaborazione con il Laboratorio Analisi Cliniche Trastevere, spera di poter stabilire un processo bidirezionale e/o circolare di scambio con tutte le parti in causa (cittadini utenti, clinici), precisando ovviamente che il contenuto degli argomenti ha carattere divulgativo ed in nessun modo può sostituire il rapporto tra paziente e curante.
L’input ad avviare questa iniziativa ci è stato dato principalmente dalla consapevolezza che, fornire adeguate informazioni sulla modalità di campionamento e su altri aspetti della fase pre-analitica, risulta di fondamentale importanza ai fini dell’affidabilità del dato di laboratorio. Intendiamo perseguire tale obiettivo in questo e nei successivi bollettini.
Ultimo aggiornamento: June, 2026